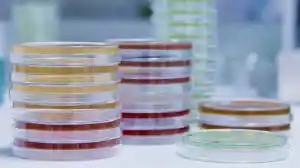

محیط کشت فنیل آلانین آگار (Phenylalanine Agar) یکی از محیطهای کشت تخصصی در میکروبیولوژی است که برای تشخیص توانایی میکروارگانیسمها در تولید آنزیم فنیل آلانین دیآمیناز طراحی شده است. این محیط کشت به دلیل قابلیتهای خاص خود در جداسازی و شناسایی باکتریهای خاص، از جمله گونههای پروتئوس، در آزمایشگاههای میکروبیولوژی بالینی و تحقیقاتی کاربرد فراوانی دارد.
برای خرید محیط کشت فنیل آلانین آگار مرک با شیمی کهن در ارتباط باشید.
021-66895887( تماس :8:30 الی 18)
واتساپ:09122885447 ( 24ساعت)
محیط کشت فنیل آلانین آگار
محیط کشت فنیل آلانین آگار یک محیط کشت افتراقی و اختصاصی است که برای شناسایی باکتریهایی که آنزیم فنیل آلانین دیآمیناز تولید میکنند، مورد استفاده قرار میگیرد. این آنزیم قابلیت تبدیل فنیل آلانین به فنیلپیروویک اسید را دارد که در حضور کلرید آهن (FeCl3) یک رنگ سبز مشخص تولید میکند. این واکنش به عنوان شاخصی برای شناسایی برخی از باکتریهای خانواده انتروباکتریاسه مانند پروتئوس، مورگانلا و پروویدنسیا به کار میرود.
شرکت شیمی کهن، نمایندگی محیط کشت در ایران می باشد. این مجموعه کلیه محصولات و مواد شیمیایی آزمایشگاهی را از جمله محصولات مرک merck ، و سیگماآلدریچ ، و محیط کشت و کلیه محصولات آزمایشگاهی و صنعتی را به مشتریان ارائه می دهد.
مشخصات شیمیایی و فیزیکی محیط کشت فنیل آلانین آگار
مشخصات شیمیایی
- پپتون: منبع اصلی نیتروژن و اسیدهای آمینه برای رشد میکروارگانیسمها.
- فنیل آلانین: بستر اصلی واکنش آنزیمی که توسط آنزیم فنیل آلانین دیآمیناز تجزیه میشود.
- آگار: عامل جامدکننده که محیط را به صورت جامد درمیآورد.
- کلرید آهن (FeCl3): معرف برای تشخیص تولید فنیلپیروویک اسید، که پس از افزودن به محیط، تغییر رنگ ایجاد میکند.
- دیهیدروژنفسفات پتاسیم: عامل بافر برای حفظ pH محیط.
- کلرید سدیم (NaCl): تنظیمکننده فشار اسمزی.
مشخصات فیزیکی
- pH محیط: 7.3 ± 0.2 در دمای 25 °C.
- ظاهر پودری: پودر کرم تا زردرنگ، یکنواخت و بدون ذرات خارجی.
- ظاهر پس از تهیه: محیط جامد به رنگ زرد شفاف.
- دمای ذخیرهسازی: 2-8 °C برای حفظ کیفیت پودر محیط.
ویژگیها و کاربردها محیط کشت فنیل آلانین آگار
ویژگیها
- اختصاصی بودن: این محیط برای شناسایی باکتریهای خاص مانند پروتئوس طراحی شده است.
- تشخیص افتراقی: قابلیت تفکیک و شناسایی گونههای تولیدکننده فنیلپیروویک اسید.
- سهولت استفاده: فرایند آمادهسازی و استفاده از این محیط ساده است.
کاربردها در صنعت شیمیایی
- تولید آنزیم: شناسایی سویههای باکتریایی با توانایی تولید فنیل آلانین دیآمیناز، که در تولید آنزیمهای صنعتی استفاده میشود.
- توسعه دارو: ارزیابی فعالیت آنزیمی در مطالعات مرتبط با بیماریهای متابولیک.
کاربردها در آزمایشگاه
- تشخیص بالینی: شناسایی عوامل بیماریزا در عفونتهای ادراری و سایر عفونتها.
- تحقیقات علمی: بررسی فعالیت آنزیمی و مسیرهای متابولیکی.
- آزمایشهای آموزشی: آموزش دانشجویان در زمینه تکنیکهای میکروبیولوژی.
نحوه آزمایش با محیط کشت فنیل آلانین آگار
- آمادهسازی محیط: پودر محیط را در آب مقطر حل کرده و در دمای 121 °C به مدت 15 دقیقه اتوکلاو کنید.
- کشت نمونه: میکروارگانیسم مورد نظر را به صورت خطی یا نقطهای روی محیط کشت دهید.
- انکوباسیون: محیط کشت را در دمای 35-37 °C به مدت 18-24 ساعت انکوبه کنید.
- افزودن معرف: پس از انکوباسیون، چند قطره محلول FeCl3 (10%) به محیط اضافه کنید.
- مشاهده نتیجه: تغییر رنگ سبز در محل رشد باکتری نشاندهنده تولید فنیلپیروویک اسید است.
محیط کشت فنیل آلانین آگار (Phenylalanine Agar) یکی از محیطهای کشت اختصاصی در میکروبیولوژی است که برای شناسایی توانایی برخی میکروارگانیسمها در دامیناسیون اسید آمینه فنیل آلانین به فنیل پیروویک اسید مورد استفاده قرار میگیرد. در این آزمایش، توانایی آنزیم فنیل آلانین دامیناز بررسی میشود. در ادامه مراحل انجام این آزمایش به صورت گامبهگام توضیح داده شده است.
مواد و تجهیزات مورد نیاز
- محیط کشت فنیل آلانین آگار آماده یا تهیهشده طبق پروتکل
- لوپ استریل یا سواب
- انکوباتور با دمای ۳۷ درجه سانتیگراد
- محلول معرف فریک کلرید (FeCl₃) با غلظت ۱۰٪
- لوله آزمایش یا پلیت استریل
- دستکش و لوازم حفاظت فردی
مراحل انجام آزمایش
1. آمادهسازی محیط کشت
- محیط کشت فنیل آلانین آگار را طبق دستورالعمل آماده کنید.
- محلول را حرارت دهید تا کاملاً حل شود و در لولههای آزمایش یا پلیت استریل بریزید.
- محیط را در شرایط استریل نگه دارید و بگذارید خنک و جامد شود.
2. تلقیح نمونه میکروبی
- از یک کلونی خالص باکتری مورد نظر با استفاده از لوپ استریل، نمونه بردارید.
- به صورت خطی یا نقطهای، نمونه را روی سطح محیط کشت تلقیح کنید.
3. انکوباسیون
- لوله یا پلیت را در انکوباتور با دمای ۳۷ درجه سانتیگراد قرار دهید.
- مدت زمان انکوباسیون معمولاً ۱۸ تا ۲۴ ساعت است.
4. افزودن معرف فریک کلرید
- پس از پایان دوره انکوباسیون، چند قطره محلول فریک کلرید ۱۰٪ را به سطح محیط اضافه کنید.
- معرف را به آرامی روی سطح محیط پخش کنید تا واکنش آغاز شود.
5. مشاهده نتایج
- تغییر رنگ محیط را بررسی کنید.
- رنگ سبز: نشاندهنده حضور فنیل پیروویک اسید و فعالیت آنزیم فنیل آلانین دامیناز است (نتیجه مثبت).
- بدون تغییر رنگ: عدم فعالیت آنزیم و نتیجه منفی.
نکات مهم در آزمایش
- تمامی مراحل باید در شرایط استریل انجام شود تا از آلودگی محیط کشت جلوگیری شود.
- معرف فریک کلرید باید تازه تهیه شده باشد تا نتایج دقیقتری حاصل شود.
- برای تأیید نتیجه، میتوانید از نمونههای کنترل مثبت و منفی استفاده کنید.
کاربرد آزمایش فنیل آلانین آگار
- شناسایی و تمایز گونههای مختلف از جنس Proteus، Providencia، و Morganella.
- بررسی فعالیت متابولیکی میکروارگانیسمها در مطالعات زیستشناسی مولکولی و میکروبیولوژی.
- کاربرد در آزمایشگاههای بالینی برای تشخیص عوامل بیماریزا.
آزمایش با محیط کشت فنیل آلانین آگار یک روش ساده و کارآمد برای بررسی فعالیت آنزیمی باکتریهاست. این تست به ویژه در شناسایی برخی گونههای خاص باکتریایی اهمیت دارد و در تحقیقات و تشخیص بالینی به طور گستردهای مورد استفاده قرار میگیرد.
ساختار و فرایند تولید محیط کشت فنیل آلانین آگار
ساختار این محیط بر پایه ترکیب مواد شیمیایی پایه با دقت بالا است. فرایند تولید شامل مراحل زیر است:
- ترکیب مواد اولیه: تمامی ترکیبات شامل پپتون، فنیل آلانین و آگار با نسبت مشخص مخلوط میشوند.
- کنترل کیفیت: آزمایش روی پودر تولیدشده برای اطمینان از یکنواختی و خلوص.
- بستهبندی: پودر در ظروف دربسته و مقاوم به رطوبت ذخیره میشود.
مزایا و معایب محیط کشت فنیل آلانین آگار
مزایا
- حساسیت و دقت بالا در تشخیص تولید آنزیم فنیل آلانین دیآمیناز.
- سهولت استفاده در محیطهای آزمایشگاهی مختلف.
- امکان شناسایی افتراقی گونههای مرتبط با بیماریهای عفونی.
معایب
- محدودیت در شناسایی باکتریهای غیرتولیدکننده این آنزیم.
- نیاز به افزودن معرف FeCl3 پس از انکوباسیون.
- هزینهبر بودن نسبت به محیطهای کشت عمومی.
خواص محیط کشت فنیل آلانین آگار
- قابلیت ذخیرهسازی طولانیمدت بدون کاهش کیفیت.
- پایداری شیمیایی در برابر تغییرات محیطی.
- امکان افزودن ترکیبات مکمل برای افزایش اختصاصیت.
پروتکل ساخت محیط کشت فنیل آلانین آگار
- مواد مورد نیاز:
- پپتون: 5 گرم
- فنیل آلانین: 2 گرم
- کلرید سدیم: 5 گرم
- دیهیدروژن فسفات پتاسیم: 1 گرم
- آگار: 15 گرم
- آب مقطر: 1 لیتر
- روش کار:
- تمامی مواد را در آب مقطر حل کرده و به خوبی مخلوط کنید.
- pH محیط را به 7.3 تنظیم کنید.
- محلول را اتوکلاو کرده و در دمای 45-50 °C در پتریدیش بریزید.
این محیط کشت به صورت آماده و پودری توسط شرکتهای تولیدکننده مواد آزمایشگاهی عرضه میشود. برای خرید:
- از نمایندگیهای معتبر داخلی و خارجی استفاده کنید.
- به مشخصات محصول از جمله تاریخ تولید و انقضا توجه کنید.
- برندهای معتبری مانند Merck، HiMedia یا Sigma-Aldrich را انتخاب کنید.
نتیجهگیری
محیط کشت فنیل آلانین آگار به دلیل ویژگیهای اختصاصی خود ابزاری کارآمد برای شناسایی و تشخیص برخی از باکتریها است. با رعایت پروتکلهای استاندارد و استفاده از محصولات با کیفیت، میتوان به نتایج دقیق و قابل اعتماد دست یافت. این محیط نه تنها در آزمایشگاههای تشخیصی، بلکه در تحقیقات علمی و صنایع مختلف کاربرد دارد و به بهبود فرایندهای زیستی و شیمیایی کمک میکند.
خرید محیط کشت فنیل آلانین آگار
شرکت شیمی که نمایندگی محیط کشت در ایران با همکاری کارشناسان مجرب خود در بخش فنی و فروش جهت تامین مواد اولیه پژوهش های تحقیقاتی ماده با کیفیت بالا و قیمت مناسب را فراهم نموده است. شما می توانید جهت خرید محیط کشت فنیل آلانین آگار با بخش فروش شرکت شیمی کهن تماس حاصل بفرمایید و پس از دریافت پیش فاکتور و اطمینان حاصل کردن از صحیح بودن شماره CAS نامبر مواد شیمیایی درخواستی اقدام به ثبت سفارش نمایید تحویل کالاهای خریداری شده و زمان تحویل آنها به صورت زیر می باشد.
ارسال کالاهای موجود در انبار: ۲۴ تا ۴۸ ساعت کاری می باشد.
روش ارسال کالا مشتریان تهران: ارسال توسط پیک
ارسال مشتریان سایر شهرها
توسط شرکت های حمل و نقل ( تیپاکس– پست– ترمینال )

قیمت فروش محیط کشت فنیل آلانین آگار
شرکت شیمی کهن یکی از بزرگترین وارد کنندگان و فروشندگان مواد شیمیایی آزمایشگاهی بخصوص فروش محیط کشت فنیل آلانین آگار می باشد. این شرکت در زمینه واردات محصولات سیگما از تجربه بسیار بالایی برخوردار است. شما می توانید جهت خرید محصولات نمایندگی مرک آلمان و تهیه این محصول (اصلی) با بخش فروش شرکت تماس گرفته و با کارشناسان این شرکت در ارتباط باشید.
همچنین از طریق کانال واتساپ شرکت نام محصول را به همراه میزان نیاز خود ارسال کنید. در کمترین زمان ممکن پاسخ استعلام خود را دریافت نمائید. امیدواریم بتوانیم با ارائه محصولات اصلی و با بهترین کیفیت شما را برای رسیدن به اهدافتان یاری نمائیم.
جهت محصولات بیشتر در نمایندگی مرک و استعلام سریع قیمت محیط کشت فنیل آلانین آگار میتوانید ازطریق کانال واتساپ شرکت با ارسال نام ماده و مقدار نیاز درکمترین زمان پاسخ استعلام خود رادریافت نمائید.
راههای ارتباطی :
021-66895887 (ساعات تماس:8:30 الی 19)
واتساپ:09122885447 (ساعات تماس 24ساعت)